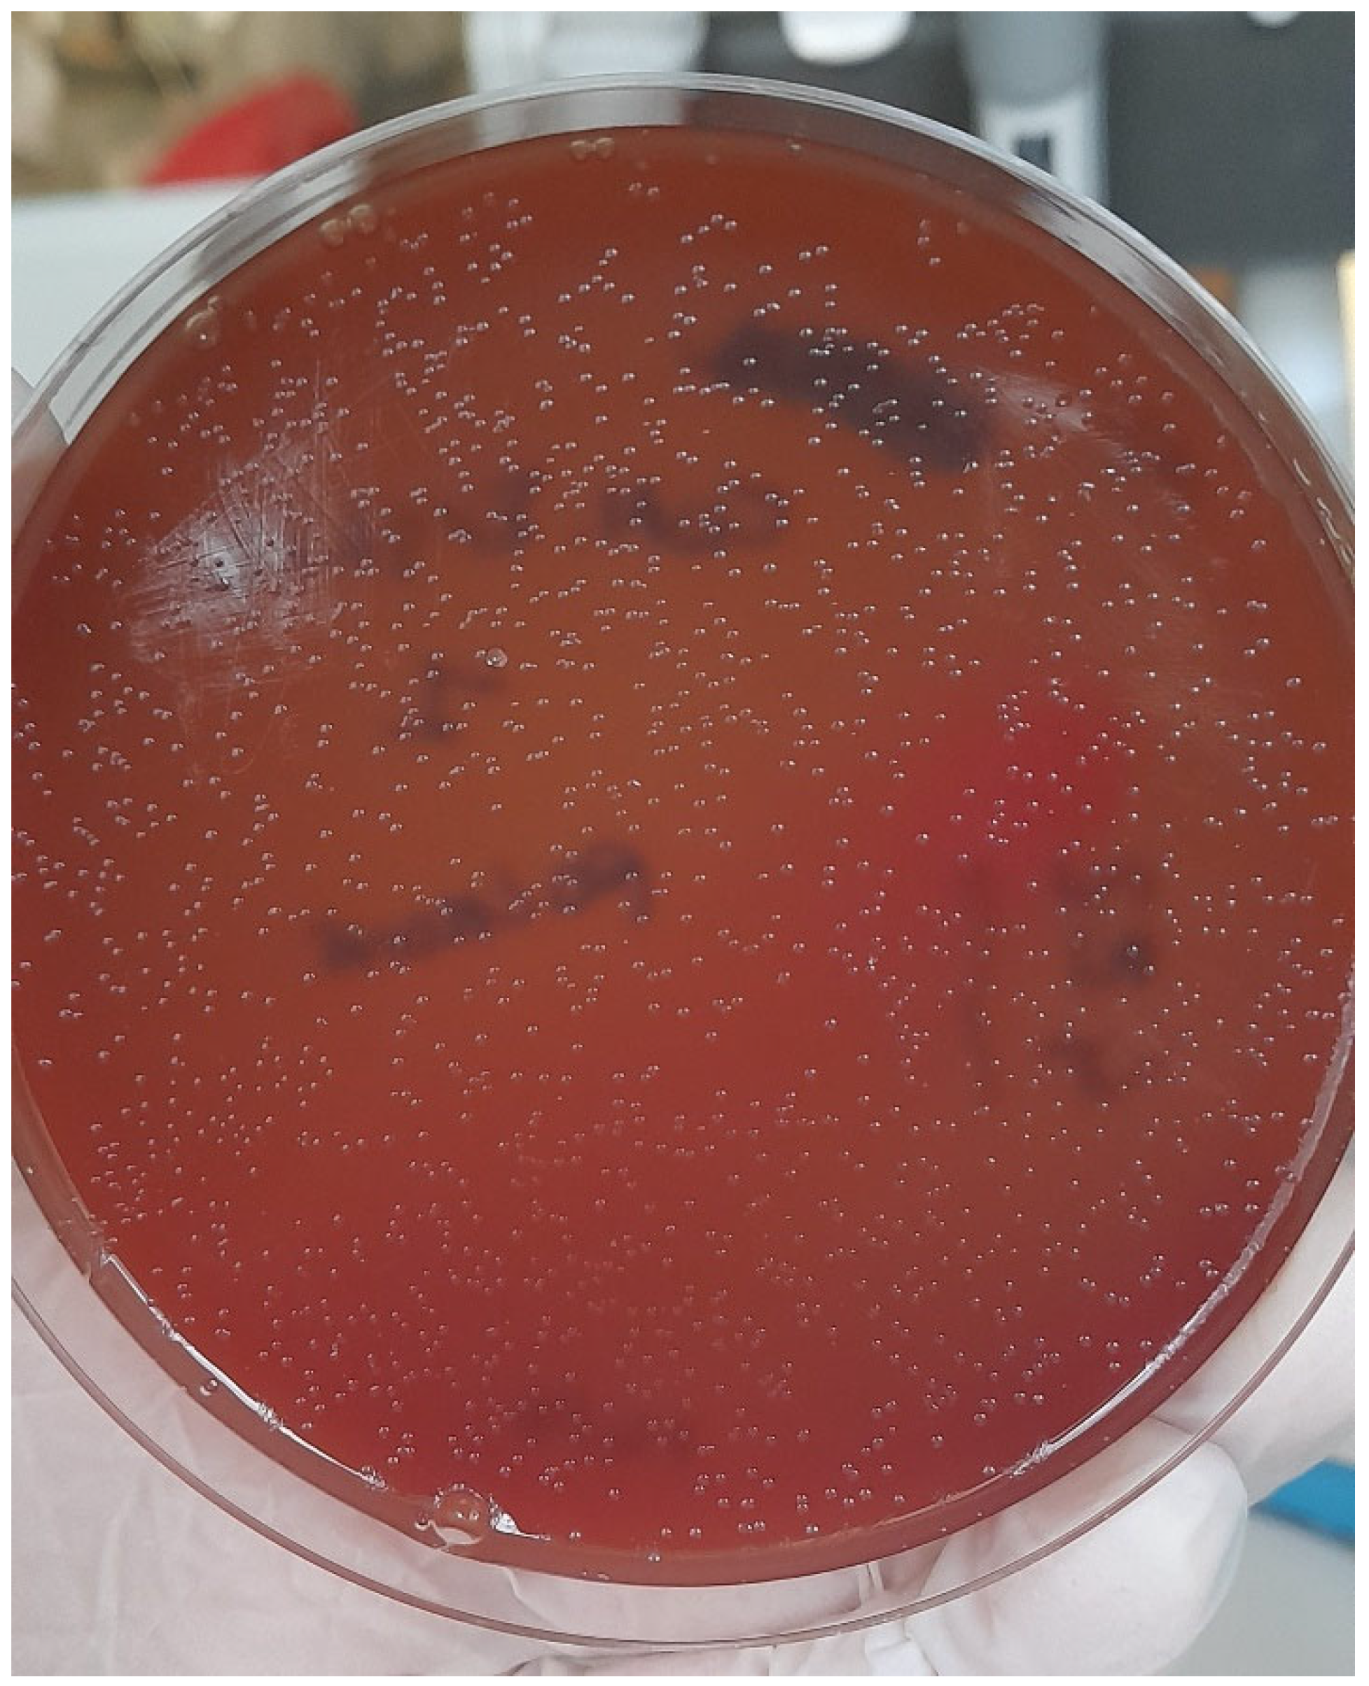
Vetsci 09 00301 g004

Spreading of Pasteurella multocida Infection in a Pet Rabbit Breeding and Possible Implications on Healed Bunnies
Abstract
1. Introduction
2. Materials and Methods
2.1. History
2.2. Clinical Findings
2.3. Bacteriology
2.4. Pathogenicity Genes Investigation
2.5. Antibiotic Susceptibility Testing
3. Results
3.1. Pasteurella multocida Detection, Capsular Type, and Pathogenicity Pattern Identification
3.2. Antibiotic Susceptibility Testing
3.3. Outcome
4. Discussion
5. Conclusions
Author Contributions
Funding
Institutional Review Board Statement
Informed Consent Statement
Data Availability Statement
Conflicts of Interest
References
- Rapporto Assalco-Zoomark ai Tempi del COVID-19. Available online: https://www.assalco.it/index.php?action=shownews&id=1&nid=10415 (accessed on 17 November 2021).
- Day, M.J. Pet-related infections. Am. Fam. Phys. 2016, 94, 794–802. [Google Scholar]
- Scoresby, K.J.; Strand, E.B.; Ng, Z.; Brown, K.C.; Stilz, C.R.; Strobel, K.; Barroso, C.S.; Souza, M. Pet ownership and quality of life: A systematic review of the literature. Vet. Sci. 2021, 8, 332. [Google Scholar] [CrossRef] [PubMed]
- Friedman, E.; Krause-Parello, C.A. Companion animals and human health: Benefits, challenges, and the road ahead for human-animal interaction. Rev. Sci. Tech. 2018, 37, 71–82. [Google Scholar] [CrossRef] [PubMed]
- Centers of Disease Control and Prevention. Available online: https://www.cdc.gov/onehealth/basics/zoonotic-diseases.html (accessed on 1 July 2021).
- Smith, K.A.; Bradley, K.K.; Stobierski, M.G.; Tengenslen, L.A. Compendium of measures to control Chlamydophila psittaci (formerly Chlamydia psittaci) infection among humans (psittacosis) and pet birds, 2005. J. Am. Vet. Med. Assoc. 2005, 226, 532–539. [Google Scholar] [CrossRef] [PubMed]
- Moroney, J.F.; Guevara, R.; Iverson, C.; Chen, F.M.; Skelton, S.K.; Messmer, T.O.; Plikaytis, B.; Williams, P.O.; Blake, P.; Butler, J.C. Detection of chlamydiosis in a shipment of pet birds, leading to recognition of an outbreak of clinically mild psittacosis in humans. Clin. Infect. Dis. 1998, 26, 1425–1429. [Google Scholar] [CrossRef]
- Circella, E.; Pugliese, N.; Todisco, G.; Cafiero, M.A.; Sparagano, O.A.; Camarda, A. Chlamydia psittaci infection in canaries heavily infested by Dermanyssus gallinae. Exp. Appl. Acarol. 2011, 55, 329–338. [Google Scholar] [CrossRef]
- Kimura, R.; Hayashi, Y.; Takeuchi, T.; Shimizu, M.; Iwata, M.; Tanahashi, J.; Makoto, I. Pasteurella multocida septicemia caused by close contact with a domestic cat: Case report and literature review. J. Infect. Chemother. 2004, 10, 250–252. [Google Scholar] [CrossRef]
- Rybarczyk, J.; Versteele, C.; Lernout, T.; Vanrompay, D. Human psittacosis. A review with emphasis on surveillance in Belgium. Acta. Clin. Belg. 2020, 75, 42–48. [Google Scholar] [CrossRef]
- Woodward, D.L.; Khakhria, R.; Johnson, W.M. Human salmonellosis associated with exotic pets. J. Clin. Microbiol. 1997, 35, 2786–2790. [Google Scholar] [CrossRef]
- Padungton, P.; Kaneene, J.B. Campylobacter spp in human, chickens, pigs and their antimicrobial resistance. J. Vet. Med. Sci. 2003, 65, 161–170. [Google Scholar] [CrossRef]
- Harris, J.M. Zoonotic diseases of birds. Vet. Clin. North Am. Small Anim. Pract. 1991, 21, 1289–1298. [Google Scholar] [CrossRef]
- Moretti, A.; Agnoletti, F.; Mancianti, F.; Nardoni, S.; Righi, C.; Moretta, I.; Morganti, G.; Papini, M. Dermatophytosis in animals: Epidemiological, clinical and zoonotic aspects. G. Ital. Dermatol. Venereol. 2013, 148, 563–572. [Google Scholar] [PubMed]
- Dipineto, L.; Rinaldi, L.; Santaniello, A.; Sensale, M.; Cuomo, A.; Calabria, M.; Menna, L.F.; Fioretti, A. serological survey for Antibodies to Encephalitozoon cuniculi in pets rabbits in Italy. Zoonoses Public Health 2008, 55, 173–175. [Google Scholar] [CrossRef] [PubMed]
- Robinson, G.; Chalmers, R.M. The European rabbit (Oryctolagus cuniculus), a source of zoonotic cryptosporidiosis. Zoonoses Public Health 2010, 57, 7–8. [Google Scholar] [CrossRef] [PubMed]
- Rewatkar, S.; Deshmukh, S.; Kumar, P.; Maske, D.; Bhangale, G. Occurrence of gastrointestinal helminths in rabbits with special reference to importance of giardia spp as parasitic zoonoses. J. Sci. Technol. 2013, 2, 142. [Google Scholar] [CrossRef]
- Broderson, J.R.; Gluckstein, F.P. Chapter 16-Zoonoses and Occupational health Considerations. In The Biology of the Laboratory Rabbit, 2nd ed.; American College of Laboratory Animal Medicine; Academic Press: Cambridge, MA, USA, 1994; pp. 355–365. [Google Scholar] [CrossRef]
- Cierniak, F.; von Arnim, F.; Heckel, G.; Ulrich, R.G.; Groschup, M.H.; Eiden, M. A putative novel hepatitis E virus genotype 3 subtype identified in rabbit, Germany 2016. Viruses 2021, 13, 1065. [Google Scholar] [CrossRef] [PubMed]
- Fritz, M.; de Riols de Fonclare, D.; Garcia, D.; Beurlet, S.; Becquart, P.; Rosolen, S.G.; Briend-Marchal, A.; Leroy, E.M. First evidence of natural SARS-CoV-2 infection in domestic rabbits. Vet. Sci. 2022, 9, 49. [Google Scholar] [CrossRef]
- Mykytyn, A.Z.; Lamers, M.M.; Okba, N.M.; Breugem, T.I.; Schipper, D.; van den Doel, P.B.; van Run, P.; van Amerongen, G.; de Waal, L.; Koopmans, M.P.G.; et al. Susceptibility of rabbits to SARS-CoV-2. Emerg. Microbes Infect. 2021, 10, 1–7. [Google Scholar] [CrossRef]
- Klotz, D.; Barth, S.A.; Baumgärtner, W.; Hewicker-Trautwein, M. Mycobacterium avium subsp. hominissuis Infection in a Domestic Rabbit, Germany. Emerg Infect Dis. 2018, 24, 596–598. [Google Scholar] [CrossRef]
- Sato, S.; Brinkerhoff, R.J.; Hollis, E.; Funada, S.; Shannon, A.B.; Maruyama, S. Detection of zoonotic bartonella pathogens in Rabbit Fleas, Colorado, USA. Emerg. Infect. Dis. 2020, 26, 778–781. [Google Scholar] [CrossRef]
- Harper, M.; Boyce, J.D.; Adler, B. Pasteurella multocida pathogenesis:125 years after Pasteur. FEMS Microbiol. Lett. 2006, 265, 1–10. [Google Scholar] [CrossRef] [PubMed]
- Massacci, F.R.; Magistrali, C.F.; Cucco, L.; Curcio, L.; Bano, L.; Mangili, P.; Scoccia, E.; Bisgaard, M.; Aalbæk, B.; Christensen, H. Characterization of Pasteurella multocida involved in rabbit infections. Vet. Microbiol. 2018, 213, 66–72. [Google Scholar] [CrossRef] [PubMed]
- Tang, X.; Zhao, Z.; Hu, J.; Wu, B.; Cai, X.; He, Q.; Chen, H. Isolation, antimicrobial resistance, and virulence genes of Pasteurella multocida strains from swine in China. J. Clin. Microbiol. 2009, 47, 951–958. [Google Scholar] [CrossRef] [PubMed]
- Ewers, C.; Lubke-Becker, A.; Bethe, A.; Kiebling, S.; Filter, M.; Wieler, L.H. Virulence genotype of Pasteurella multocida strains isolated from different hosts with various disease status. Vet. Microbiol. 2006, 114, 304–317. [Google Scholar] [CrossRef] [PubMed]
- Katoch, S.; Sharma, M.; Patil, R.D.; Kumar, S.; Verma, S. In vitro and in vivo pathogenicity studies of Pasteurella multocida strains harbouring different ompA. Vet. Res. Commun. 2014, 38, 183–191. [Google Scholar] [CrossRef] [PubMed]
- Hatfaludi, T.; Al-Hasani, K.; Boyce, J.D.; Adler, B. Outer membrane proteins of Pasteurella multocida. Vet. Microbiol. 2010, 144, 1–17. [Google Scholar] [CrossRef] [PubMed]
- Deeb, J.B. Chapter 17—Respiratory disease and pasteurellosis. In Ferrets, Rabbits, and Rodents: Clinical Medicine and Surgery, 3rd ed.; W.B. Saunders: Saint Louis, MO, USA, 2012; pp. 172–182. [Google Scholar]
- Weber, D.J.; Wolfson, J.S.; Swartz, M.N.; Hooper, D.C. Pasteurella multocida infections. Report of 34 cases and review of the literature. Medicine 1984, 63, 133–154. [Google Scholar] [CrossRef]
- Wilson, B.A.; Ho, M. Pasteurella multocida: From zoonosis to cellular microbiology. Clin. Microbiol. Rev. 2013, 26, 631–655. [Google Scholar] [CrossRef]
- Liu, W.; Chemaly, R.F.; Tuohy, M.J.; LaSalvia, M.M.; Procop, G.W. Pasteurella multocida urinary tract infection with molecular evidence of zoonotic transmission. Clin. Inf. Dis. 2003, 36, 58–60. [Google Scholar] [CrossRef][Green Version]
- Abrahamian, F.M.; Goldstein, E.J. Microbiology of animal bite wound infections. Clin. Microbiol. Rev. 2011, 24, 231–246. [Google Scholar] [CrossRef]
- Wilkie, I.W.; Harper, M.; Boyce, J.D.; Adler, B. Pasteurella multocida: Diseases and Pathogenesis; Springer: Heidelberg/Berlin, Germany, 2012; pp. 1–22. [Google Scholar]
- Holst, E.; Rollof, J.; Larsson, L.; Nielsen, J.P. Characterization and distribution of Pasteurella species recovered from infected humans. J. Clin. Micobiol. 1992, 30, 2984–2987. [Google Scholar] [CrossRef] [PubMed]
- Klein, N.C.; Cunha, B.A. Pasteurella multocida pneumonia. Semin. Respir. Infect. 1997, 12, 54–56. [Google Scholar] [PubMed]
- Townsend, K.M.; Boyce, J.D.; Chung, J.Y.; Frost, A.J.; Adler, B. Genetic organization of Pasteurella multocida cap Loci and development of a multiplex capsular PCR typing system. J. Clin. Microbiol. 2001, 39, 924–929. [Google Scholar] [CrossRef] [PubMed]
- Lainson, F.A.; Thomson, N.; Rowe, H.; Langford, P.R.; Aitchison, K.D.; Donachie, W.; Kroll, J.S. Occurrence of [copper, zinc]-cofactored Superoxide dismutase in Pasteurella haemolytica and its serotype distribution. FEMS Microbiol. Lett. 1996, 142, 11–17. [Google Scholar] [CrossRef]
- Doughty, S.W.; Ruffolo, C.G.; Adler, B. The type 4 fimbrial subunit gene of Pasteurella multocida. Vet. Microbiol. 2000, 72, 79–90. [Google Scholar] [CrossRef]
- The European Committee on Antimicrobial Susceptibility Testing. Breakpoint Tables for Interpretation of MICs and Zone Diameters. Version 12.0. Available online: http://www.eucast.org (accessed on 1 January 2022).
- Clinical Laboratory and Standards Institute. M02-A12. Performance Standards for Antimicrobial Disk Susceptibility Tests-Twelfth Edition. Available online: https://clsi.org (accessed on 1 January 2015).
- Broome, R.L.; Brooks, D.L. Efficacy of enrofloxacin in the treatment of respiratory pasteurellosis in rabbits. Lab. Anim Sci. 1991, 41, 572–576. [Google Scholar]
- Ujvári, B.; Weiczner, R.; Deim, Z.; Terhes, G.; Urbán, E.; Tóth, A.R.; Magyar, T. Characterization of Pasteurella multocida strains isolated from human infections. Comp. Immunol. Microbiol. Infect. Dis. 2019, 63, 37–43. [Google Scholar] [CrossRef]
- Smith, E.; Miller, E.; Munoz Aguayo, J.; Figueroa, C.F.; Nezworski, J.; Studniski, M.; Wileman, B.; Johnson, T. Genomic diversity and molecular epidemiology of Pasteurella multocida. PLoS ONE 2021, 16, e0249138. [Google Scholar] [CrossRef]
- Jaglic, Z.; Kucerova, Z.; Nedbalcova, K.; Hlozek, P.; Bartos, M. Identification of Pasteurella multocida serogroup F isolates in rabbits. J. Vet. Med. B 2004, 51, 467–469. [Google Scholar] [CrossRef]
- Jekl, V. Respiratory disorders in rabbits. Vet. Clin. North Am. Exot. Anim Pract. 2021, 24, 459–482. [Google Scholar] [CrossRef]
- Lennox, A.M. Respiratory disease and pasteurellosis. In Ferrets, Rabbits, and Rodents, 3rd ed.; Quesenberry, K.E., Carpenter, J.W., Eds.; WB Saunders Co: Philadelphia, PA, USA, 2012; Volume 41, pp. 205–216. [Google Scholar]
- Ferreira, T.S.; Felizardo, M.R.; Sena de Gobbi, D.D.; Gomes, C.R.; de Lima Nogueira Filsner, P.H.; Moreno, M.; Paixao, R.; de Jesus Pereira, J.; Moreno, A.M. Virulence genes and antimicrobial resistance profiles of Pasteurella multocida strains isolated from rabbits in Brazil. Sci. World. J. 2012, 2012, 1–6. [Google Scholar] [CrossRef]
- Shirzad Aski, H.; Tabatabaei, M. Occurrence of virulence-associated genes in Pasteurella multocida isolates obtained from different hosts. Microb. Pathog. 2016, 96, 52–57. [Google Scholar] [CrossRef] [PubMed]
- Atashpaz, S.; Shayegh, J.; Hejazi, M.S. Rapid virulence typing of Pasteurella multocida by multiplex PCR. Res. Vet. Sci. 2009, 87, 355–357. [Google Scholar] [CrossRef] [PubMed]

| Target | Primers | Sequences | Amplimer Size |
|---|---|---|---|
| Pasteurella multocida specie | KMT1T7 | ATCCGCTATTTACCCAGTGG | 460 bp |
| KMT1SP6 | GCTGTAAACGAACTCGCCAC | ||
| Capsular type A | CAPA-FWD | TGCCAAAATCGCAGTCAG | 1044 bp |
| CAPA-REV | TTGCCATCATTGTCAGTG | ||
| Capsular type B | CAPB-FWD | CATTTATCCAAGCTCCACC | 760 bp |
| CAPB-REV | GCCCGAGAGTTTCAATCC | ||
| Capsular type D | CAPD-FWD | TTACAAAAGAAAGACTAGGAGCCC | 657 bp |
| CAPD-REV | CATCTACCCACTCAACCATATCAG | ||
| Capsular type E | CAPE-FWD | TCCGCAGAAAATTATTGACTC | 511 bp |
| CAPE-REV | GCTTGCTGCTTGATTTTGTC | ||
| Capsular type F | CAPF-FWD | AATCGGAGAACGCAGAAATCAG | 851 bp |
| CAPF-REV | TTCCGCCGTCAATTACTCTG |
| Virulence Factor | Primer | Sequence | Amplimer Size | |
|---|---|---|---|---|
| A | Dermonecrotic toxin | ToxA-F ToxA-R | CTTAGATGAGCGACAAGGTT GGAATGCCACACCTCTATA | 865 bp |
| Trasferrin binding protein | TbpA-F TbpA-R | TTGGTTGGAAACGGTAAAGC TAACGTGTACGGAAAAGCCC | 728 bp | |
| Type 4 fimbriae | Fim4-F Fim4-R | TGTGGAATTCAGCATTTTAGTGTGTC TCATGAATTCTTATGCGCAAAATCCTGCTGG | 866 bp | |
| Superoxide dismutate | SodA-F SodA-R | TACCAGAATTAGGCTACGC GAAACGGGTTGCTGCCGCT | 361 bp | |
| Filamentous hemagglutinin | Pfha-F Pfha-R | AGCTGATCAAGTGGTGAAC TGGTACATTGGTGAATGCTG | 275 bp | |
| B | Iron acquisition | ExbB-F ExbB-R | TTGGCTTGTGATTGAACGC TGCAGGAATGGCGACTAAA | 283 bp |
| Hemoglobin binding protein | HgbB-F HgbB-R | ACCGCGTTGGAATTATGATTG CATTGAGTACGGCTTGACAT | 788 bp | |
| Neuroaminidase | NanB-F NanB-R | GTCCTATAAAGTGACGCCGA ACAGCAAAGGAAGACTGTCC | 554 bp | |
| Putative nonspecific tight adherence protein D | TadD-F TadD-R | TCTACCCATTCTCAGCAAGGC ATCATTTCGGGCATTCACC | 416 bp | |
| Lipoprotein B | PlpB-F PlpB-R | TTTGGTGGTGCGTATGTCTTCT AGTCACTTTAGATTGTGCGTAG | 282 bp | |
| Superoxide dismutate | SodC-F SodC-R | AGTTAGTAGCGGGGTTGGCA TGTGCTGGGTGATCATCATG | 235 bp | |
| C | Outer membrane protein 87 | Oma87-F Oma87-R | ATGAAAAAACTTTTAATTGCGAGC TGACTTGCGCAGTTGCATAAC | 948 bp |
| Fimbriae | FimA-F FimA-R | CCATCGGATCTAAACGACCTA AGTATTAGTTCCTGCGGGTG | 866 bp | |
| Neuroaminidase | NanH-F NanH-R | GAATATTTGGGCGGCAACA TTCTCGCCCTGTCATCACT | 360 bp | |
| ferric uptake regulation protein | Fur-R Fur-F | GTTTACCGTGTATTAGACCA CATTACTACATTTGCCATAC | 244 bp |
| Diameter of Inhibition Zone (mm) | |||
|---|---|---|---|
| Antibiotic (Acronym) | Susceptibility Breakpoint | Aerobic Conditions | Microaerophilic Conditions |
| Ciprofloxacin (CIP) | 27 | 58 | 62 |
| Trimetophim-Sulfametoxazole (SXT) | 24 | 28 | 28 |
| Enrofloxacin (ENR) | 28 | 48 | 52 |
| Ampicillin (AMP) | 27 | 32 | 30 |
| Tetracycline (TE) | 24 | 46 | 44 |
| Nalidixic acid (NA) | 23 | 50 | 52 |
| Gentamicin (CN) | 20 | 22 | 26 |
| Amoxicillin-Clavulanic acid (AMC) | 27 | 36 | 30 |
| Imipenem (IPM) | 23 * | S | 40 |
| Cefotaxime (CTX) | 26 | S | 54 |
| Tilmicosin (TIL) | 14 | 28 | 27 |
| Amoxicillin (AX) | 17 | 33 | 36 |
| Doxycycline (DO) | 23 | 36 | 40 |
| Meropemem (MEM) | 23 * | 42 | 48 |
| Azitromycin (AZM) | 20 | 44 | 40 |
| Erytrhomycin (E) | 27 | 32 | 36 |
Publisher’s Note: MDPI stays neutral with regard to jurisdictional claims in published maps and institutional affiliations. |
© 2022 by the authors. Licensee MDPI, Basel, Switzerland. This article is an open access article distributed under the terms and conditions of the Creative Commons Attribution (CC BY) license (https://creativecommons.org/licenses/by/4.0/).
Share and Cite
D’Amico, F.; Casalino, G.; Bozzo, G.; Camarda, A.; Lombardi, R.; Dimuccio, M.M.; Circella, E. Spreading of Pasteurella multocida Infection in a Pet Rabbit Breeding and Possible Implications on Healed Bunnies. Vet. Sci. 2022, 9, 301. https://doi.org/10.3390/vetsci9060301
D’Amico F, Casalino G, Bozzo G, Camarda A, Lombardi R, Dimuccio MM, Circella E. Spreading of Pasteurella multocida Infection in a Pet Rabbit Breeding and Possible Implications on Healed Bunnies. Veterinary Sciences. 2022; 9(6):301. https://doi.org/10.3390/vetsci9060301
Chicago/Turabian StyleD’Amico, Francesco, Gaia Casalino, Giancarlo Bozzo, Antonio Camarda, Roberto Lombardi, Michela Maria Dimuccio, and Elena Circella. 2022. "Spreading of Pasteurella multocida Infection in a Pet Rabbit Breeding and Possible Implications on Healed Bunnies" Veterinary Sciences 9, no. 6: 301. https://doi.org/10.3390/vetsci9060301
APA StyleD’Amico, F., Casalino, G., Bozzo, G., Camarda, A., Lombardi, R., Dimuccio, M. M., & Circella, E. (2022). Spreading of Pasteurella multocida Infection in a Pet Rabbit Breeding and Possible Implications on Healed Bunnies. Veterinary Sciences, 9(6), 301. https://doi.org/10.3390/vetsci9060301

